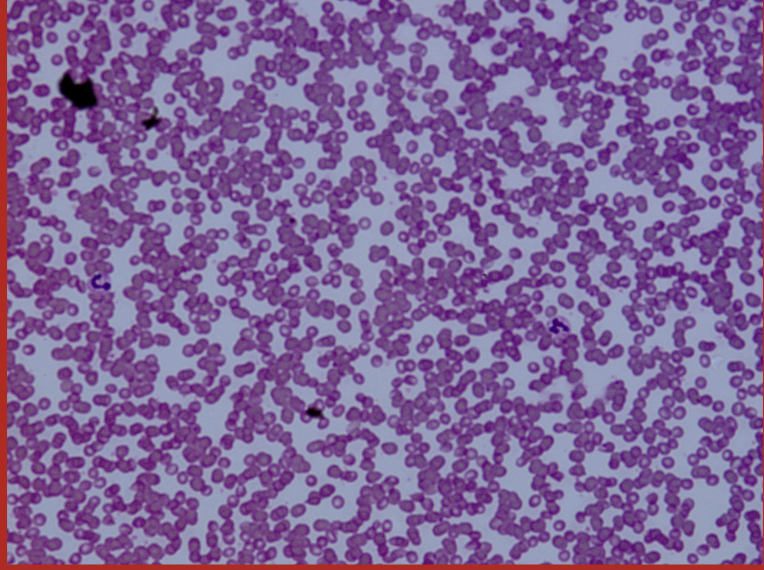
knowt flashcard image

Specific Protists (Images)
0.0(0)
0.0(0)
Card Sorting
1/15
There's no tags or description
Looks like no tags are added yet.
Study Analytics
Name | Mastery | Learn | Test | Matching | Spaced |
|---|
No study sessions yet.
16 Terms
1
New cards
Euglenozoans - Trypanosoma lewisi (zoomed out in blood)
2
New cards
Labeled Trypanosoma levisi

3
New cards
Stramenopiles - Diatoms (zoomed out)

4
New cards
Stramenopiles - Diatoms (labeled)

5
New cards
Phaeophyta - Brown Algae - Sargassum?

6
New cards
Paramecium Caudatum (zoomed out)

7
New cards
Paramecium Caudatum labeled

8
New cards
Foraminiferans
one image example:

9
New cards
Radiolarians (zoomed out)

10
New cards
Radiolarian (labeled)

11
New cards
Amoeba (zoomed out)

12
New cards
Amoeba (labeled)

13
New cards
Rhodophyta - Red algae

14
New cards
Spirogrya - Green Algae (zoomed out)

15
New cards
Spirogrya - Green Algae (zoomed in)

16
New cards